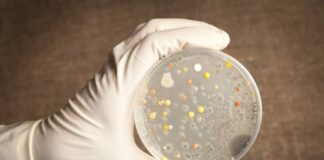
FG alerts Nigerians on outbreak of Anthrax

td-cloud-library domain was triggered too early. This is usually an indicator for some code in the plugin or theme running too early. Translations should be loaded at the init action or later. Please see Debugging in WordPress for more information. (This message was added in version 6.7.0.) in /home/osrcng/public_html/wp-includes/functions.php on line 6131Ondo State Radiovision Corporation is the Nations Star Station aimed at delivering the latest news with up-to-date accuracy while also giving you the best in entertainment, politics and much more.
Contact us: contact@osrc.ng
© 2022 - Ondo State Radiovision Corporation